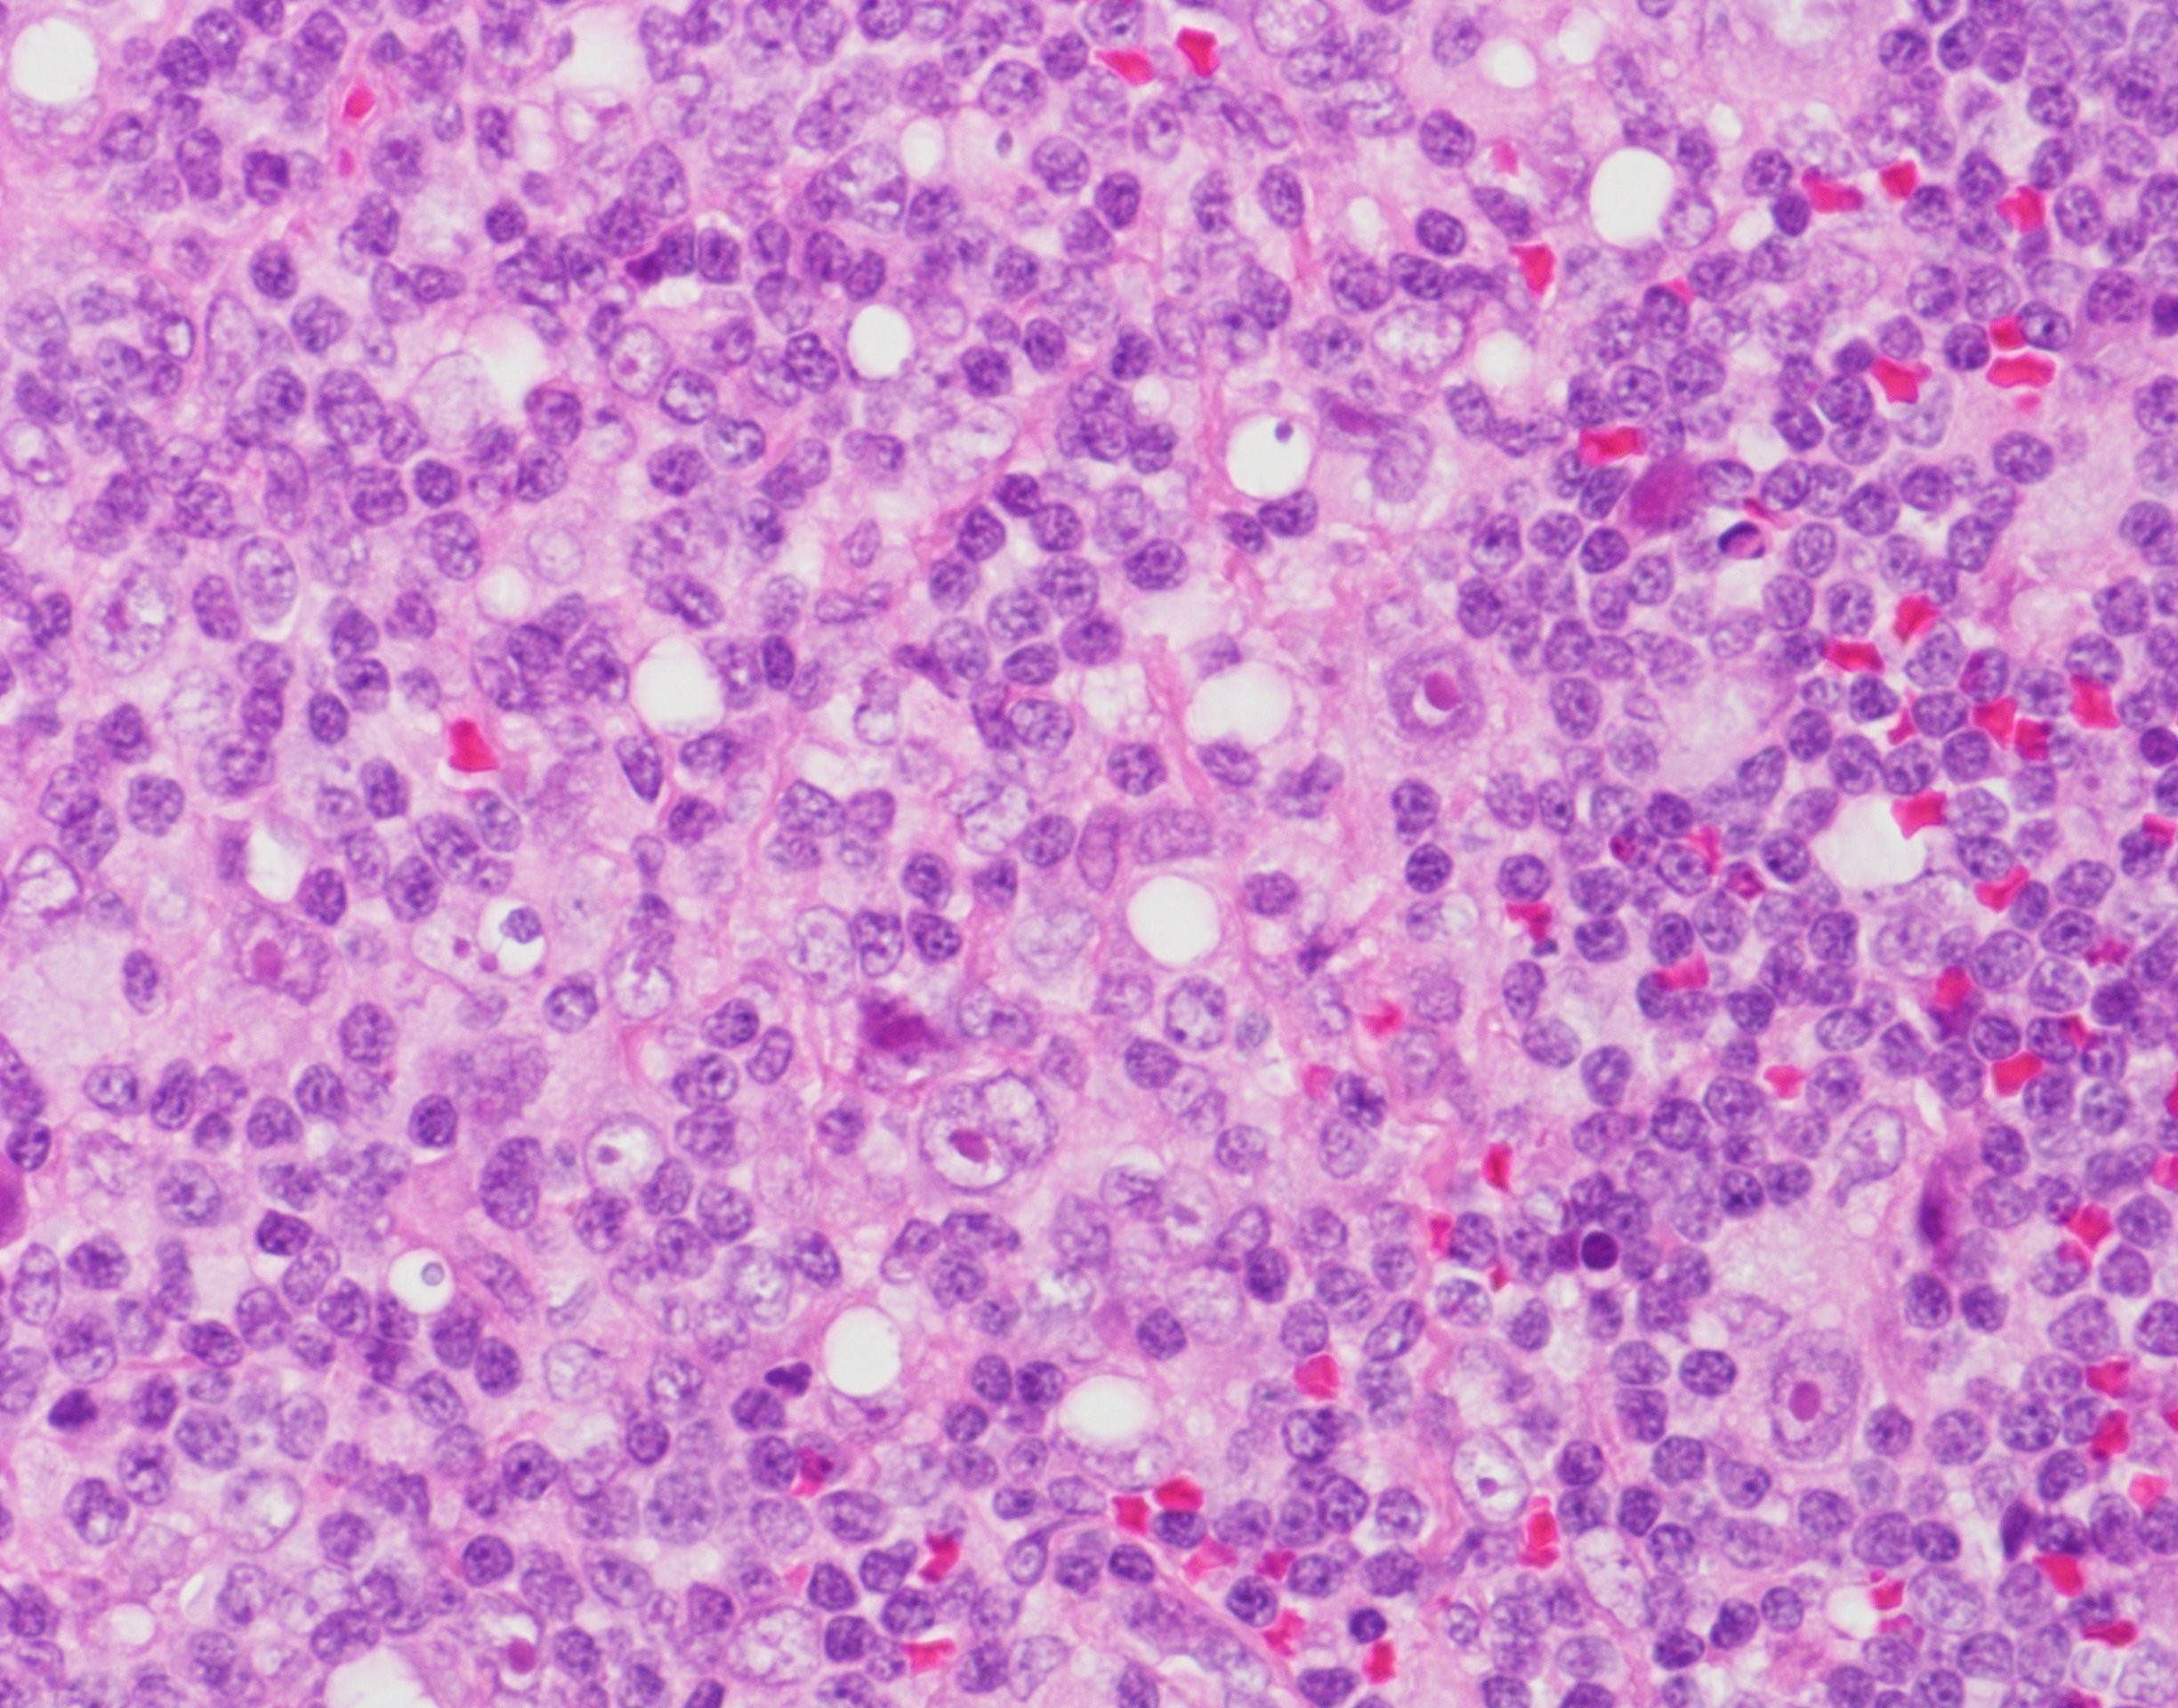
NHLのその他の補完療法

ホメオパシーが非ホジキンリンパ腫 (NHL) を治療、さらには治癒できると信じている人もいます。これが真実であるという証拠や、ホメオパシーがあらゆる病状を治療または治癒できるという証拠はありません。
これは国立補完統合医療センター (NCCIH) によるものです。
ホメオパシーは代替医療の特殊な形式です。これは、健康な人に症状を引き起こす非常に少量の物質を摂取するだけで、病気の人を治療できるという考えに基づいています。その原理は、科学者が人体について知っていることに反するものです。
ホメオパシーはホリスティック医療とは異なります。ホリスティック医学では、人間の全人格を考慮する必要があります。 NHL への総合的なアプローチには、誰かの精神的健康と栄養のサポートと並行して、がん自体を標的とする治療が含まれる可能性があります。
この記事では、ホメオパシーがNHLに役立つかどうか、そのリスク、および人々が検討したいと考えている他の補完療法について検討します。
ホメオパシーは代替医療の一種で、1700年代後半にドイツで発祥しました。これは 2 つの重要な原則で構成されます。 1つ目は「似たものは似たものを治す」という考え方です。これは、健康な人に症状を引き起こす物質が、その物質に関連する病気を治療できることを意味します。
2つ目の原則は「無限小の法則」です。これは、物質が薄められるほど、その効力が高まることを意味します。
ホメオパシーの支持者は、ホメオパシーの実践は、体の自然な免疫または治癒プロセスを開始または活性化することによって機能すると信じています。しかし、NICCHは、その中心となる概念が現代の科学的な医学理解と矛盾していると述べています。
ホメオパシーのレメディには、比較的無害な植物から有毒物質や動物に至るまで、多くの物質が含まれている場合があります。
ホメオパシー療法の可能性を調査する多数の臨床試験にもかかわらず、ホメオパシーがあらゆる症状に対してプラセボよりも効果的であるという決定的な証拠はありません。
NHL は、リンパ球と呼ばれる特定の種類の白血球で発生するがんのグループを指します。これらの細胞は、免疫系の一部であるリンパ系の一部です。 NHL には、関与する細胞の種類や位置などのいくつかの要因に応じて、多くの種類があります。
治療には通常、化学療法または放射線で癌細胞を殺すことが含まれます。場合によっては、免疫系ががん細胞自体を殺すのを助けるモノクローナル抗体療法も含まれる場合があります。
ホメオパシーは、レメディが非常に希釈されているため、これらの治療法と同じ効果がある可能性は低いです。
ポジティブに見えるケーススタディもあります。 2019年のドイツの事例研究では、大細胞B細胞非ホジキンリンパ腫の63歳の女性が、コニウムC 30(毒ヘムロック)を1粒ずつ2週間毎日摂取した。
研究者らは、影響を受けたリンパ節を切除して顕微鏡で観察したところ、腫瘍の証拠はなかったと述べています。
しかし、これは必ずしもホメオパシーが癌を治癒したことを意味するものではありません。まれではありますが、NHL の自然寛解も可能です。 2015年と2017年のケーススタディでは、NHL患者が治療を受けずに回復した例が記録されています。
さらに、この研究はツガが改善の原因であることを証明しておらず、1 人の個人にのみ焦点を当てています。大規模な試験のみが、治療法が確実に機能し、安全であるという証拠を提供できます。
ホメオパシーが本当にNHLの症状を軽減できるかどうかは不明です。現在、ホメオパシーのレメディを使用した後に気分が良くなったと報告する人々は、プラセボ効果を経験している可能性が高いようです。
ただし、プラシーボ効果は依然として有益である可能性があります。症状を軽減したり、症状に対処しやすくしたりするように見える場合があります。
ホメオパシーを利用すると、自分に起こっていることをよりコントロールできるようになり、病気による心理的影響も軽減される可能性があると感じる人もいるかもしれません。
Cancer Research UK によると、ホメオパシーががん治療に伴う副作用の軽減に役立つかどうかを調査した小規模な研究がいくつかあります。どれも決定的となるのに十分な証拠を提供していない。
ホメオパシーにはいくつかのリスクが伴います。
ホメオパシー製品には、極度に希釈した濃度の有効成分が含まれるように意図されていますが、一部のホメオパシー製品には、害を引き起こす可能性のあるはるかに高いレベルの有効成分が含まれている場合があります。これらには次のものが含まれます。
- ナスなどの有毒植物
- ヒ素などの重金属
- 薬と相互作用する可能性のある物質
さらに、食品医薬品局 (FDA) は、米国で販売されているホメオパシーであると主張する製品を評価しません。これは、製品が購入可能になる前に、製品が安全か純粋かどうかをテストしないことを意味します。
ホメオパシー製品には、謳われている成分が含まれていない場合があります。 FDAはこれまでに、細菌による汚染やリストに掲載されていない抗生物質が存在する可能性を理由に、ブランドが製品を回収していることについて声明を発表している。
また、ホメオパシー製品を優先して標準的な治療を避けることにも重大なリスクがあります。このアプローチにはがんが進行する危険性があります。
現在の研究によると、がんを治癒できる補完療法はありません。しかし、安全で科学的根拠に基づいた補完療法は、がんの症状、治療の副作用、またはがんの状態による精神的影響に対処するのに役立つ可能性があります。
NICCH と米国癌協会による補完医療アプローチは、癌治療に取り組む人々に次のような助けとなる可能性があります。
ホメオパシーは、科学界で物議を醸している代替療法です。 NHLを含むあらゆる病状を治療できるという証拠はありません。
ただし、一部の人にとっては、治療をよりコントロールできていると感じるのに役立つ場合があります。プラセボ効果を通じて、症状や治療の副作用にも影響を与える可能性があります。
ホメオパシーのレメディには、薬と相互作用する可能性のある成分が含まれているものもあるため、服用する前に医師と相談することが重要です。がんの治療をホメオパシーだけに依存しないことも重要です。
非ホジキンリンパ腫に対するホメオパシー・関連動画
参考文献一覧
- https://www.sciencedirect.com/science/article/pii/S2214541915000176
- https://www.nccih.nih.gov/health/tips/things-you-need-to-know-about-cancer-and-complementary-health-approaches
- https://www.nccih.nih.gov/health/homeopathy
- https://www.ncbi.nlm.nih.gov/pmc/articles/PMC7365555/
- http://www.medicalnewstoday.com/articles/286745
- https://www.ncbi.nlm.nih.gov/pmc/articles/PMC7253376/
- https://www.cancer.org/cancer/non-hodgkin-lymphoma/about/what-is-non-hodgkin-lymphoma.html
- https://www.fda.gov/drugs/information-drug-class/homeopathy-products
- https://www.hindawi.com/journals/crihem/2017/2676254/
- https://www.cancer.org/treatment/treatments-and-side-effect/treatment-types/complementary-and-integrative-medicine/complementary-and-alternative-methods-and-cancer/what-methods-are-おそらく安全である可能性が高い.html
- https://www.cancerresearchuk.org/about-cancer/cancer-in-general/treatment/complementary-alternative-therapies/individual-therapies/homeopathy